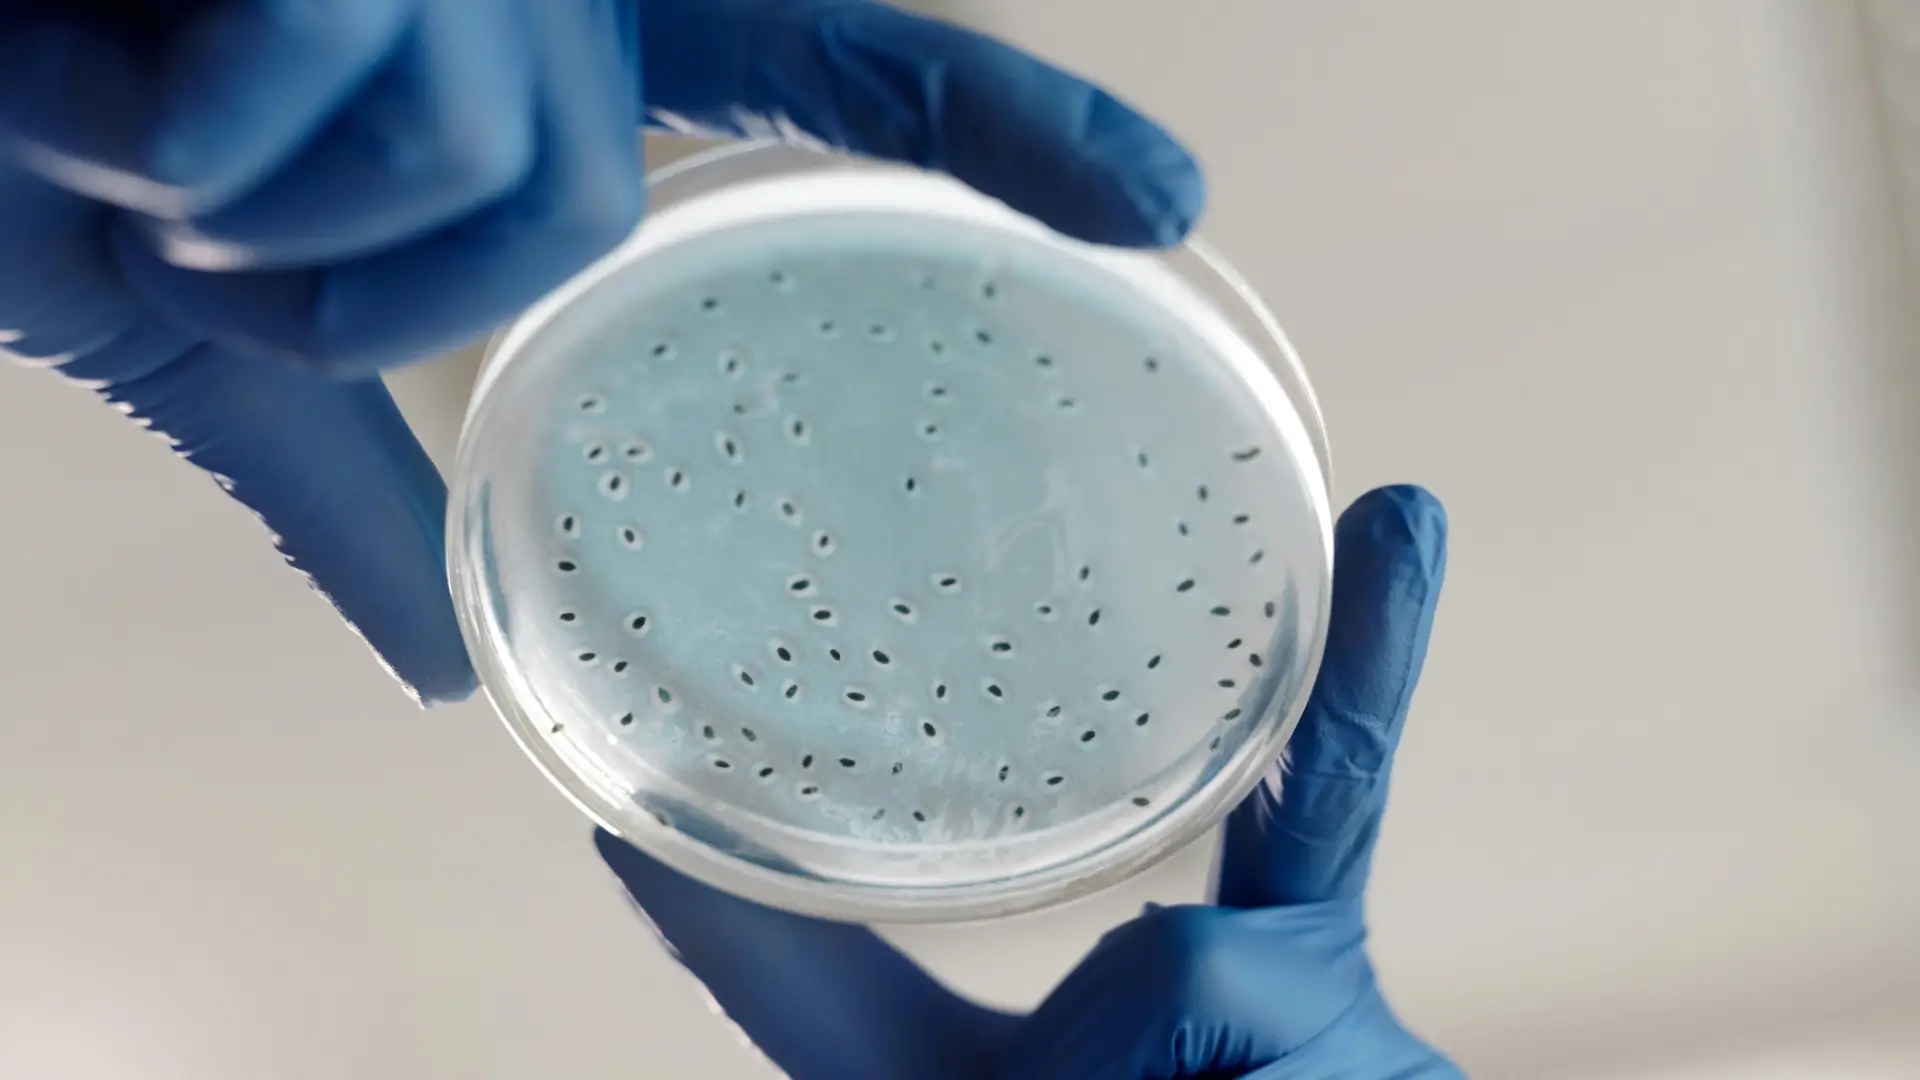

Bachelor of Medicine, Bachelor of Surgery (MBBS) is a 5.5-year undergr...
Empowering Future Doctors with
Excellence in Education and Compassionate Care
The SIMS & RC is a premier institution established to provide quality medical education and affordable healthcare. Located on the Mangalore–Udupi Highway, it houses a super-speciality teaching hospital with 20+ departments and admits 250 MBBS students annually. Affiliated to Srinivas University and approved by the National Medical Commission, SIMS&RC blends modern infrastructure, advanced medical technology, and a strong social commitment to train competent doctors destined to serve the country.